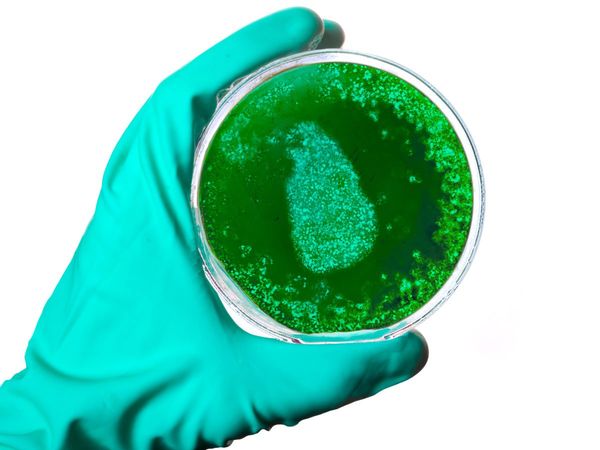
what is Aspergillosis green fungus cases In India Symptoms

Green Fungus in India: ब्लैक फंगस से कई गुना खतरनाक है ग्रीन फंगस, इंदौर में आया पहला केस, जानें लक्षण
Green Fungus cases In India And Symptoms: ब्लैक, व्हाइट और यलो फंगस के बाद भारत में ग्रीन फंगस ने भी दस्तक दे दी है, विशेषज्ञों के मुताबिक यह ब्लैक फंगस से कई गुना खतरनाक है।
- इंदौर से आया ग्रीन फंगस का पहला मामला, ये ब्लैक फंगस से है कई गुना खतरनाक।
- पिछले डेढ़ माह से चल रहा था मरीज का श्री अरबिंदो अस्पताल में इलाज।
- कोरोना संक्रमित होने पर मरीज के फेफड़े हो गए थे पूरी तरह डैमेज।
भारत अभी भी कोराना वायरस की मार से उभरने के लिए जद्दोजहद कर रहा है। हालांकि वैक्सीनेशन और कोरोना के प्रति तमाम अहतियात के जरिए दूसरी लहर अब समाप्ति की ओर है। लेकिन इसी बीच ब्लैक, व्हाइट और यलो फंगस ने भारत की मुश्किलों को और भी बढ़ा दिया है। म्यूकोर्मिकोसिस यानि ब्लैक फंगस अभी तक सबसे घातक फंगस में से एक रहा है, जो कोराना से ठीक होने के बाद लोगों को अपनी चपेट में ले रहा है। जिसमें डायबिटीज के मरीजों की संख्या सबसे अधिक है। वहीं आपको बता दें ब्लैक, व्हाइट और यलो फंगस के बाद भारत में ग्रीन फंगस ने भी दस्तक दे दी है, जिसने डॉक्टरों की चिंता को और भी बढ़ा दिया है।
मध्य प्रदेश के इंदौर में रहने वाले 34 वर्षीय व्यक्ति में कोविड से ठीक होने के करीब डेढ़ माह बाद ग्रीन फंगस की पुष्टि की गई है। बेहतर इलाज के लिए संक्रमित व्यक्ति को मुंबई के दूसरे अस्पताल में शिफ्ट किया गया है। चिकित्सकों के मुताबिक यह ब्लैक फंगस से कई गुना खतरनाक है। श्री अरबिंदो इंस्टीट्यूट ऑफि मेडिकल साइंस के चेस्ट डिजीज के एचओडी डॉक्टर रवि डोसी ने बताया कि कोरोना से संक्रमित होने के दौरान व्यक्ति में ब्लैक फंगस के लक्षण देखे गए थे। जिसके बाद उसका परीक्षण किया गया, टेस्ट के दौरान व्यक्ति में ब्लैक फंगस के बजाए ग्रीन फंगस (एम्परगिलोसिस) की पुष्टि की गई है।
डॉ रवि डोसी के मुताबिक व्यक्ति पोस्ट कोविड मरीज था। उसके फेफड़ों व साइनस में एसरपरजिलस फंगस मिलने के बाद उसका उपचार अलग किया गया। पिछले 90 दिनों से व्यक्ति का कोविड का इलाज चल रहा था, संक्रमण के दौरान मरीज के फेफड़े पूरी तरह डैमेज हो गए थे। डिस्चार्ज होने के बाद व्यक्ति में यह बीमारी सामने आई है। वहीं आपको बता दें फंगस के हरे रंग कारण इसे ग्रीन फंगस का नाम दिया गया है। विशेषज्ञों के मुताबिक यह जानने के लिए अधिक अध्ययन की आवश्यकता है कि क्या कोविड-19 से उबरने वाले लोगों में ग्रीन फंगस का संक्रमण अन्य रोगियों से अलग है।
ग्रीन फंगस क्या है, what is green fungus, what is Aspergillosis
विशेषज्ञों के मुताबिक एस्परगिलोसिस एस्परगिलस के कारण होने वाला एक संक्रमण है। एस्परगिलस कई तरह के होते हैं। अधिकांश लोग बिना बीमार हुए प्रतिदिन एस्परगिलस बीजाणुओं में सांस लेते हैं। हालांकि कमजोर रोग प्रतिरोध क्षमता या फेफड़ों से संबंधित बीमारी से ग्रस्त लोगों में इस भयावह फंगस के संक्रमण का खतरा अधक हो सकता है।
green fungus symptoms, ग्रीन फंगस के लक्षण
एस्परगिलोसिस में विभिन्न प्रकार के लक्षण होते हैं। इस दौरान संक्रमित व्यक्ति में अस्थमा के समान खांसी, बुखार, सासं लेने में परेशानी, छाती में दर्द, नाक का बहना, सिर दर्द, सूंघने की क्षमता में कमी, खांसी में खून आना, नाक से खून बहना, कमजोरी, वजन तेजी से कम होना आदि लक्षण शामिल हैं।





